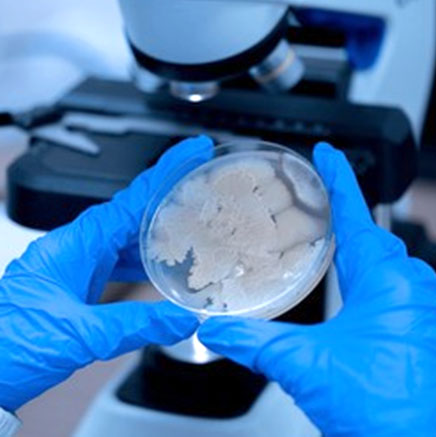

16th National Biennial Conference of ISMM
Dear Members and Delegates,
Very warm greetings from the team of the ISMM 16th Biennial Conference 2027 from 4th to 7th February 2027. It gives us immense pleasure to invite you to this Conference at Rajendra Institute of Medical Sciences, Ranchi, Jharkhand.
Ranchi is the capital city of Jharkhand, situated in the Chhotanagpur valley. It is famous for its natural beauty and cultural significance. It is renowned for its cascading waterfalls, lush green landscapes, serene lakes, significant religious & cultural sites, making it a popular destination.
We promise to treat you with a plethora of information and also provide you with an opportunity to learn from some of the most eminent mycologists from across India and abroad. We also extend an invitation to all of you to enjoy the scenic beauty of Jharkhand, India.

Why Attend ISMM 2027
Scientific Excellence
Engage with leading experts and discover the latest advances in medical mycology and fungal infections.
Workshops & Demos
Participate in hands-on workshops focusing on lab diagnostics, clinical skills, and real-world case studies.
Eminent Speakers
Learn from top national and international faculty in the field of mycology, infectious diseases, and pathology.
Join the National Biennial Conference
Registrations Now Open!
ISMM 2027 is for all clinical and scientific professionals involved in the diagnosis and management of invasive fungal infection...FOR REGISTRATION AND MORE DETAILS, Keep Log in...






